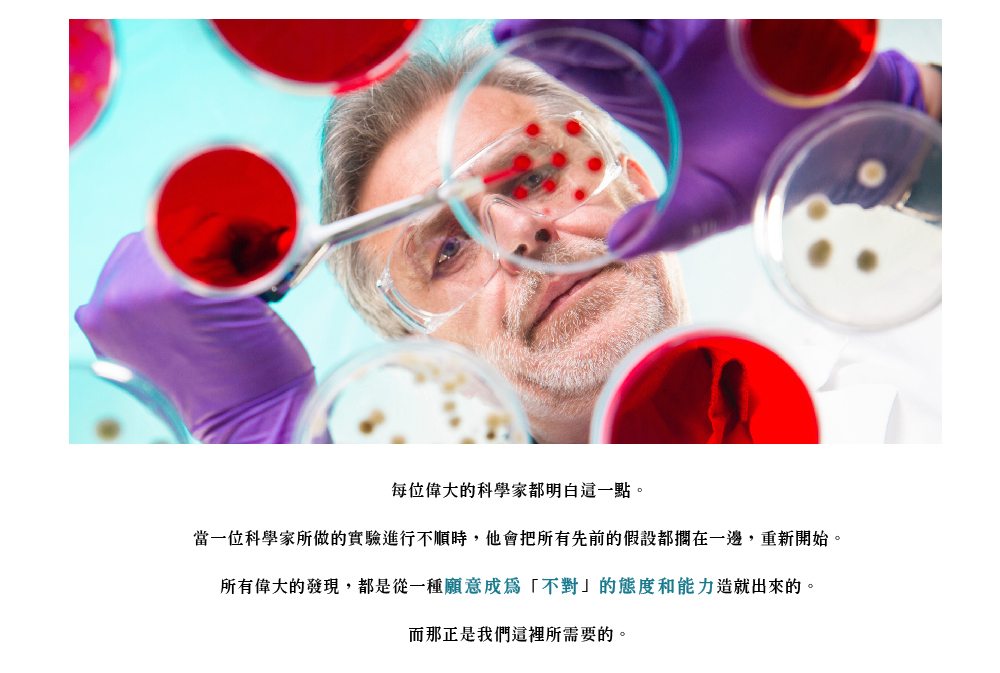

如何讓自己更認識神?如何讓自己更能辨識出神的訊息、聽見神的聲音?如果說,連《聖經》都並非權威可靠的來源的話,那什麼才是我該傾聽的權威可靠來源(authoritative sources)呢?
文字是最不可靠的真理供應工具?讓我們聽聽神怎麼說:
聽神談【如果連聖經都並非權威可靠的來源,那什麼才是?】
尼爾:為什麼有些人,就以基督為例,仿佛比別的人更能聽到你的訊息?
因為有些人願意真正傾聽。他們願意傾聽,縱使當訊息看起來似乎是可怕或瘋狂,或根本就錯誤時,他們仍然願對這樣的訊息保持開放的心。
尼爾:我們應該傾聽神,縱使當他所說的內容似乎是錯誤時?
尤其是、特別是當那內容似乎是錯誤時。如果你認為在每一事件上你都是對的,那還有誰需要跟神談話呢?
儘管去對所有你知道的事採取行動。但要注意的是,有史以來你們就一直在那樣做,而看看世界淪為什麼模樣。很清楚地,你們一直都錯失了某東西(Clearly, you have missed something.)。很顯然地,有些你們並不了解的東西。那些你們確實了解的東西,必然會看起來是對的,因為「對」是一個你們用來指明你們所同意的東西(because “right”is a term you use to designte something with which you agree)。 所以,那些你們一直錯失的東西,在最初會顯得是「錯」的。
你唯一能向前邁進的一條路是問你自己:「如果每件我認為是『錯』的事,實際上是『對』的話,會變成怎麼樣?」。每位偉大的科學家都明白這一點。當一位科學家所做的實驗進行不順時,他會把所有先前的假設都擱在一邊,重新開始。所有偉大的發現,都是從一個願意成為「不對」的態度和能力(a willingness, and ability, to not be right)造就出來的。而那正是我們這裡所需要的。
你無法認識神,除非你停止告訴自己「你已經認識神」。除非你不再認為你已然聽見神,否則你無法聽見神。(You cannot know God until you’ve stopped telling yourself that you already know God. You cannot hear God until you stop thingking that you’ve already heard God.)
除非你不再告訴我你的真理,否則我無法告訴你我的真理。(I cannot tell you My Truth until you stop telling Me yours.)
尼爾:但是我(所知)對神的真理是來自於你。
是誰說的?
尼爾:別人。
是什麼樣的別人。
尼爾:領袖們。牧師們。教士們。神父們。書籍。還有,看在上帝份上,《聖經》!
那些並非權威可靠的來源。(Those are not authoritative sources.)
尼爾:不是嗎?
不是。
尼爾:那什麼才是?
聆聽你的感受(feelings)。傾聽你的最高想法(Highest Thoughts)。傾聽你的經驗(experiences)。每當你發覺這些(內在的感受、最高想法和經驗)與任何你的老師們告訴你的,或你在書裡讀到的話語不同時,就忘掉那些話語。文字話語是最不可靠的真理供應工具。(Words are the least reliable purveyor of Truth.)
摘自《與神對話 I》第1章

Neale: Why do some people, take Christ, for example, seem to hear more of Your communication than others?
Because some people are willing to actually listen. They are willing to hear, and they are willing to remain open to the communication even when it seems scary, or crazy, or downright wrong.
Neale:We should listen to God even when what’s being said seems wrong?
Especially when it seems wrong. If you think you are right about everything, who needs to talk with God?
Go ahead and act on all that you know. But notice that you’ve all been doing that since time began. And look at what shape the world is in. Clearly, you’ve missed something. Obviously, there is something you don’t understand. That which you do understand must seem right to you, because “right” is a term you use to designate something with which you agree. What you’ve missed will, therefore, appear at first to be “wrong.”
The only way to move forward on this is to ask yourself, “What would happen if everything I thought was “wrong” was actually “right”?” Every great scientist knows about this. When what a scientist does is not working, a scientist sets aside all of the assumptions and starts over. All great discoveries have been made from a willingness, and ability, to not be right. And that’s what’s needed here.
You cannot know God until you’ve stopped telling yourself that you already know God. You cannot hear God until you stop thinking that you’ve already heard God.
I cannot tell you My Truth until you stop telling Me yours.
But my truth about God comes from You.
Who said so?
Neale:Others.
What others?
Neale:Leaders. Ministers. Rabbis. Priests. Books. The Bible, for heaven’s sake!
Those are not authoritative sources.
Neale:They aren’t?
No.
Neale:Then what is?
Listen to your feelings. Listen to your Highest Thoughts. Listen to your experience. Whenever any one of these differ from what you’ve been told by your teachers, or read in your books, forget the words. Words are the least reliable purveyor of Truth.
